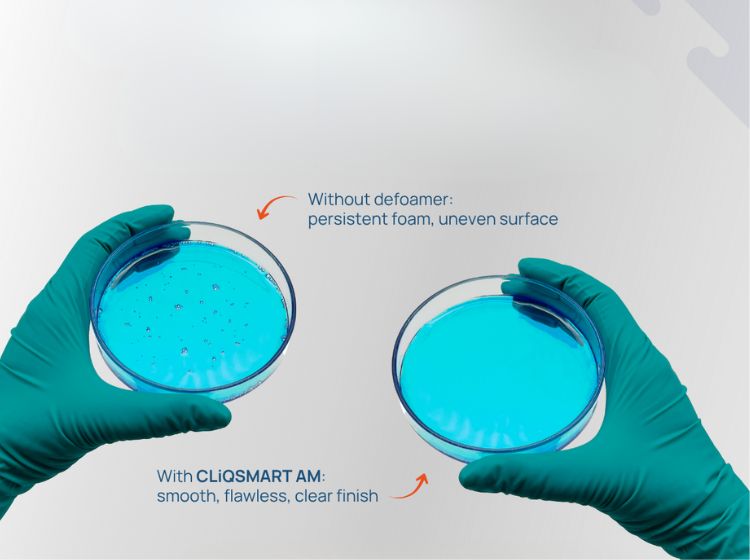

Chemtrade appointed South African distributor for BIOSILICO bio-based silica
March 2026 Chemtrade has been appointed the authorised distributor for BIOSILICO® silica solutions in South Africa. The appointment brings advanced technology from BSB Nanotechnology to the local market. It also marks BSB Nanotechnology’s first expansion into Africa. This strengthens access for South African manufacturers to… Read More »Chemtrade appointed South African distributor for BIOSILICO bio-based silica